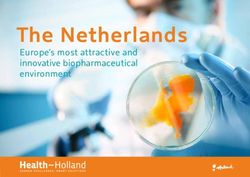
The Netherlands Europe's most attractive and innovative biopharmaceutical environment - Health Holland

How does the land supply system affect the business of UK speculative housebuilding? - An evidence review
←
→
Page content transcription
If your browser does not render page correctly, please read the page content below
How does the land supply
system affect the business of
UK speculative housebuilding?
An evidence review
Dr Sarah Payne (University of Sheffield), Dr Bilge Serin, Dr Gareth James & Professor David Adams (University of Glasgow)
28 February 2019
housingevidence.ac.ukAbout the author(s) Dr Sarah Payne is a Co-Investigator at the UK Collaborative Centre for Housing Evidence and is based in the Department of Urban Studies and Planning at the University of Sheffield. Dr Bilge Serin is a Research Associate at the UK Collaborative Centre for Housing Evidence and is based at the University of Glasgow. Dr Gareth James is a Knowledge Exchange Associate at the UK Collaborative Centre for Housing Evidence and is based at the University of Glasgow. Professor David Adams is a Co-Investigator at the UK Collaborative Centre for Housing Evidence and holds the Ian Mactaggart Chair of Property and Urban Studies at the University of Glasgow. Acknowledgements We are grateful to the ESRC, AHRC and the Joseph Rowntree Foundation for financial support through the UK Collaborative Centre for Housing Evidence. We are also grateful to Homes for Scotland and the Home Builders Federation for helping to organise roundtables with their members respectively in November and December 2018, and for the feedback from all those who attended and participated in these discussions. 2
housingevidence.ac.uk
Contents
Executive summary................................................................................................................................................................................................................Page 6
1. Introduction............................................................................................................................................................................................................................Page 8
1.1 Research aims..............................................................................................................................................................................................................Page 9
1.2 Methods...................................................................................................................................................................................................................... Page 10
1.3 Report outline.......................................................................................................................................................................................................... Page 11
2. How has the industry been studied?.................................................................................................................................................................. Page 13
2.1 Theoretical perspectives........................................................................................................................................................................................... Page 13
2.2 Disciplinary perspectives................................................................................................................................................................................. Page 14
2.3 Methods..................................................................................................................................................................................................................... Page 14
2.4 Significant policies.................................................................................................................................................................................................Page 15
3. The evidence...................................................................................................................................................................................................................... Page 16
3.1 Land acquisition methods and processes............................................................................................................................................. Page 16
3.1.1 Evidence on the use of options, conditional contracts and the land use planning process......................... Page 16
3.1.2 Evidence on the use of networks and contacts.........................................................................................................................Page 17
3.1.3 Evidence on the behavioural practices of housebuilders in relation to brownfield and greenfield
development sites.................................................................................................................................................................................................. Page 18
3.1.4 Summary............................................................................................................................................................................................................ Page 19
3.2 The composition of land portfolios and questions of land ‘banking’..................................................................................Page 20
3.2.1 Evidence on the purpose and size of land banks.....................................................................................................................Page 20
33.2.2 Evidence on the impact of land portfolios and land banking on design outcomes and sector
innovation.................................................................................................................................................................................................................... Page 22
3.2.3 Research and evidence gaps around land portfolios and land banking................................................................... Page 22
3.2.4 Summary...........................................................................................................................................................................................................Page 23
3.3 Product selection.................................................................................................................................................................................................. Page 24
3.3.1 Evidence on standardisation................................................................................................................................................................. Page 24
3.3.2 Evidence on customisation.....................................................................................................................................................................Page 27
3.3.3 Evidence on the influencing effects of regulatory and technological changes on the mode of
delivery...........................................................................................................................................................................................................................Page 27
3.3.4 Summary...........................................................................................................................................................................................................Page 29
3.4 The speed of delivery of new private housing...................................................................................................................................Page 30
3.4.1 Factual evidence on build-out rates.................................................................................................................................................Page 30
3.4.2 Market-based explanations of build-out rates............................................................................................................................Page 31
3.4.3 Alternative explanations of build-out rates.................................................................................................................................. Page 32
3.4.4 Potential solutions........................................................................................................................................................................................ Page 33
3.4.5 Summary...........................................................................................................................................................................................................Page 34
4. Conclusion........................................................................................................................................................................................................................... Page 35
Bibliography.............................................................................................................................................................................................................................Page 36
Appendix: CaCHE evidence review guidance.....................................................................................................................................................Page 40
4housingevidence.ac.uk
5Executive summary The supply of new housing presents a major challenge in the UK, aggravating the housing shortage. The lag between planning approvals and housing completions is often cited as one explanation for the slow speed of new private housing delivery. Yet, build out rates form only one part of a much more complex set of processes that determine the speed and mode of housing delivery. In this evidence review, we evaluate some of the key strategies of the speculative housebuilding sector, in relation to land, planning and development, drawing especially on 62 key publications dating from between 1997 and 2018. The report is presented in four sections. Section 1 introduces the research aims, methods and report outline. In Section 2, we look at how the sector has been studied over the past two decades. We find that most of the literature on the housebuilding industry is atheoretical, multidisciplinary and tends to employ the same methods of research, or the same combinations of methods. These observations reveal key research challenges and important lessons for future research on the housebuilding sector in the UK and elsewhere. In Section 3, we present existing evidence on the following four key areas of enquiry: land acquisition methods and processes; the composition of land portfolios and questions of land ‘banking’; product selection and the mode of housing delivery, including construction methods; and the speed of housing delivery, including build out rates. Section 4 concludes. First, the evidence shows that UK housebuilders most commonly use options and conditional contracts to access and acquire land for residential development. They also rely more on networks and contacts than on markets to source land. However, conventional land acquisition strategies vary according to the type of site. The strategies and skills used for greenfield sites, for example, differ from those required for brownfield sites. The size and type of the firm can also have an influence on how housebuilders respond to policy initiatives designed to influence their business practices, including, but not exclusively, in relation to land acquisition. The evidence shows that smaller housebuilders tend to be disadvantaged by these processes. Second, existing evidence shows that land ‘banking’ serves a number of functions but specific practices vary between firms and regions. There is some evidence to say that housebuilders’ business models do not depend on profiting from land banks; instead, evidence suggests that land ‘banking’ is a response to planning uncertainties. However, land banks also help to control costs, increase margins, provide security against company debts and foster confidence among the firms’ investors. The evidence shows considerable variation in the size of land banks (usually measured in terms of the number of years’ supply). The distribution of strategic and short-term land held by housebuilders in their land portfolios also varies between firms. Those housebuilders with a higher proportion of their developments on brownfield sites tend to bank more land than firms with fewer brownfield developments, primarily due to the risks associated with brownfield development. There is some evidence, too, that developing on existing land banks can allow more time for design. However, overall, there are clear research and evidence gaps on land portfolios and land banking: most of the existing evidence is partial and much of the information on the function of land banks comes from now dated studies. Third, we provide evidence of an embedded culture of standardisation in the mode of delivery of new housing which is resistant to significant public policy interventions. Greater levels of customisation are difficult to achieve given the issues that exist around funding and regulatory frameworks and capturing user needs. There is a reluctance among housebuilders to depart from standard house types. Moreover, the evidence suggests that design codes make the build process more demanding, and that ‘smart parcelization’ can increase the diversity of product. There are also practical difficulties around the efficacy of technological innovations associated with low and zero carbon housing which are difficult to resolve since they increase risk. Besides, housebuilders generally argue that there is no clear demand from their customers for greater customisation or energy efficient technologies. Fourth, we found substantial recent evidence on the speed of delivery of new private housing. We provide 6
housingevidence.ac.uk
evidence to suggest that sales rates and site size are two key factors in determining build-out rates. However,
the evidence also suggests that the relationship between site size and output is not proportionate, which
can be explained partly by the number of different sales outlets on each site. There is conflicting evidence
on whether greenfield or brownfield sites are built out more quickly; although sites with more affordable
housing do tend to be developed faster. For large development sites to achieve faster build-out rates would
probably require the site to be split up into two or three sales outlets. We also compare market-based
explanations for slow build-out rates (housing demand, land supply, competition between firms) with those
based on technical and other reasons (the nature of the production process and other specific constraints).
The report concludes by highlighting four points for reflection. First, much of the existing evidence is dated,
except for that on the speed of delivery of new private housing. Second, the evidence has a tendency to
homogenise the industry and favour the mainstream volume builders. Third is the tendency for research
to be geographically benign and underplay the distinctions in policy and spatiality: there was very little, if
any discussion of Welsh or Northern Irish housebuilding in the literature. Finally, the review has pointed to a
key research challenge for future work on the housebuilding industry, which is that of developing a richer
theoretical understanding of how the industry operates as a basis for stronger empirical investigation.
71. Introduction The supply of new housing is one of the biggest political and societal challenges facing the UK. A recent housing White Paper setting out the UK government’s plans to reform the housing market and boost supply in England stated that “The housing market in this country is broken, and the cause is very simple: for too long, we haven’t built enough homes” (DCLG, 2017). Housing supply shortage is also a major concern in other parts of the UK. Bramley (2018) estimated that 4.75 million households across Great Britain are either homeless or living in precarious and unsuitable accommodation and that 380,000 new homes need to be built every year for the next 15 years. This figure includes the supply of new social housing, with specific provision of housing for shared ownership and immediate affordable rent. As Payne (2016: 7) noted “Britain’s dominant speculative housebuilders alone will not be able to build out in sufficient volume to meet the country’s housing supply needs”. In England, at least, the growing lag between planning approvals and housing completions is given as one explanation for the sluggish speed of new housing delivery (Bentley, 2017), and is of increasing political and popular interest (Letwin, 2018). Letwin concluded that the homogeneity of housing products on large development sites combined with limits on the market absorption rate serves to slow down build out rates. Yet, build out rates form only one part of a much more complex set of processes that determine the speed and mode of speculative housing delivery. How housebuilders interact with land markets, make product selection choices and manage construction programmes are also likely to influence supply outcomes. Our market-led housing system relies heavily on the private sector to deliver new homes. These private housebuilders, motivated primarily by profit and return on capital, are key delivery agents of new homes, producing anywhere between 70% and 80% of the total housing output in any given year.1 To deliver new homes at an acceptable profit, housebuilders must make assumptions on the quantity, expected price and sales rate well before any homes are built in order to generate competitive land bids and secure their raw materials. Once planning permission is granted and land purchased, housebuilders must wait until the houses are constructed and sold, hopefully at the rate and price predicted beforehand, to achieve their desired profits. Any rise in underlying land prices between site purchase and eventual house sales can boost profits significantly. This process of speculative housing provision requires risk taking and profit making by market actors, yet also is subject to intervention and regulation by the state. The ability of government policy to influence market behaviour, together with the impact of broader structural changes in the economic, demographic and political contexts of housing provision, mean that many diverse factors can shape supply outcomes. This may go some way to explaining why issues of housing supply remain so difficult to address. Yet, understanding these dynamic state-market relations is the very reason why we are interested in the behaviours and attitudes of speculative housebuilders. Indeed, without knowing how speculative housebuilders acquire, process and build out housing land, policy-makers cannot fully address the UK’s housing supply problems. 1 See Ministry of Housing, Communities and Local Government - Live Tables on House Building: New Dwellings Completed, available at https://www.gov.uk/government/statistical-data-sets/live-tables-on-house-building 8
housingevidence.ac.uk
1.1 Research aims
It is for these reasons that we have chosen to undertake a systematic review of existing evidence on the
current operation and limitations of the speculative housing supply system. Our aim is to evaluate some
of the key strategies of the speculative housebuilding sector, especially in relation to land, planning
and development. To do this, we concentrate on the following four key areas of enquiry:
l Land acquisition methods and processes;
l The composition of land portfolios and questions of land ‘banking’;
l Product selection and the mode of housing delivery, including construction methods; and,
l The speed of housing delivery, including build-out rates.
By following these four lines of enquiry, this review, unlike many other studies, covers the full extent of the planning
and delivery process from the acquisition of land through to the completion and delivery of new housing stock.
Although housebuilders may not be surprised by what we report, our target audience also includes planners
and policymakers who are perhaps less familiar with the industry, and indeed anyone concerned with increasing
housing supply but not directly employed by, or working with, a speculative housebuilder. In this context,
Payne (2013: 59) called for “a greater understanding by policymakers and planners of the behavioural practices
of speculative housebuilders and the institutional environment within which they operate”. She cautioned
that “policymakers seeking to challenge the dominant traditions of speculative housebuilders may reinforce
institutional rigidity and undermine genuine and significant institutional change” and suggests that policymakers
and planners need to “work closely with the grain of the industry to harness speculative housebuilders effectively
in their desire to accelerate housebuilding in what might be a potentially risk-averse future” (Payne, 2013: 59).
Although some industry reports present an expert but somewhat uncritical view of the housebuilding industry
(see, for example, Nathaniel Lichfield and Partners, 2016), others call for a greater understanding of the role of
planners in ensuring adequate supply of housing land and better recognition of the social, environmental and
economic constraints upon allocating land (MacDonald and Kilman, 2007). The role of planners falls outside the
remit of this report, although we hope to examine the evidence in relation to planning processes in future work.
Instead, our overarching aim is to generate a more rounded understanding of the UK speculative housebuilding
industry among all those involved in, or working with the industry, including planners and policymakers.
91.2 Methods We conducted a systematic review of literature on UK housebuilding published between 1997 and 2018. A guidance document was produced to establish the protocol to be implemented in the review process. This approach has been developed more generally by CaCHE in order to facilitate all its systematic evidence reviews undertaken by multidisciplinary research teams. The guidance document compiles key information about the review including the review scope (e.g. research aim, questions and objectives); the review steps; sources to be reviewed (e.g. academic indices, journals and publications by key institutions); keywords and queries to be run for reviewing sources; the inclusion-exclusion criteria to be applied for selecting the evidence; quality criteria for the appraisal of studies to be included in the review; and a work plan. Implementation of this guidance fosters transparency in the review processes while also facilitating a systematic interaction among the research team (see Appendix). The research team collectively agreed the guidance for this project and took the key strategic decisions such as selecting academic indices and journals. Three bibliographic sources were selected, namely Scopus, Web of Science and SocINDEX. Scopus and Web of Science were selected according to the results of a CaCHE literature mapping exercise which identified that these two indices cover a substantial amount of published academic material (Serin, 2018a); while SocINDEX was chosen due to its subject relevance. Academic journals were selected from a list compiled for a more generic mapping report on housing supply literature (Serin, 2018b). Additional journals were identified by the research team based on their expertise and knowledge of the field (see Appendix). In addition, the research team piloted the review in order to identify keywords and test the data extraction categories before starting the review process. This piloting phase was conducted by selecting eight articles from a wider pool of academic publications on the housebuilding industry. The review process entailed five key stages. First, the academic indices were reviewed by running keyword queries on title, abstract, and stated keywords of the articles. The first-phase inclusion-exclusion criteria were applied to the returns and a core database was created (see Appendix for the inclusion-exclusion criteria). Second, selected journals were identified by using the same keywords and the returns were reviewed according to the first-phase inclusion-exclusion criteria. Selected articles from journal reviews were then included in the core database. Third, the grey literature was searched, beginning with newspaper reviews. Nexis, which is an online search tool for making systematic searches in the newspapers published in the UK, was used for this phase of the review. The research team initially aimed to explore newspaper investigations and reports. However, this search did not produce any substantive new sources material that could be added to our core database. The Nexis search did, however, point us to grey literature produced by other institutions referred to, or quoted in, the news content. We therefore traced the original sources of grey literature systematically and added these sources to the core database. The cut-off date for search media was June 2018. Fourth, full-texts of the documents in the core database were reviewed according to the data extraction categories, quality appraisal checklist and second-phase inclusion-exclusion criteria (see Appendix for these criteria). As a result of this assessment, some publications were excluded from the core database (due to low quality or irrelevant content) and no data extraction applied on them. We were left with 62 primary sources (50 academic and 12 from the grey literature) and a list of 8 secondary sources. About 25% of the reference material comes from sources produced by the authors of this report or other CaCHE co-investigators, which reflects the capacity of CaCHE. It is worth noting however that all publications considered for this review were subject to strict inclusion-exclusion criteria and quality assessment, and, crucially, none of the authors was responsible for reviewing the quality of their own work. Also crucially in this phase of the review were two sense-check meetings, one in Edinburgh and one in London, undertaken with the participation of senior practitioners in the industry. The aim of these meetings was to find out what, if anything, we might have missed in our literature search and to gather feedback from industry experts before going forward to the next step of the review. Fifth, based on the data extracted over the review, a synthesis of the identified evidence was 10
housingevidence.ac.uk
produced. Table 1.1 sets out for the number of returns in initial reviews and final number of publications
reviewed, while the full list of publications reviewed can be found in the bibliography.
1.3 Report outline
The remainder of this report is structured as follows. Section 2 presents a brief account of how the
UK housebuilding industry has been studied over the past two decades. In particular, we provide
a useful summary of the theoretical and disciplinary perspectives evident in the literature. We also
consider some of the methods most commonly used by those researching the housebuilding industry
in the UK. Section 2 reveals some key challenges and lessons for future research in this field.
Section 3 comprises the main findings in relation to the four key areas of enquiry listed above. First, we provide
evidence on housebuilders’ land acquisition methods and processes. Here we draw primarily on three key
publications, which, when taken together, reveal some of the strategies used by housebuilders to access
and acquire land for residential development. Second, we examine the evidence on the composition of land
portfolios and questions of land ‘banking’. We include evidence on two key issues: the purpose and size of land
banks, and their relationship to design outcomes and sector innovation. We then consider the main research
and evidence gaps around land portfolios and land banking. Third, we provide evidence on product selection
and the mode of housing delivery, including construction methods. And, fourth, we examine evidence on
the speed of housing delivery, including build out rates, and consider some potential policy solutions.
In each section, we present only the evidence that we have been able to extract from the
literature. We do not attempt to make any claims beyond this; instead, our goal is to provide an
objective account of what is already known in relation to each of these four lines of enquiry.
The report concludes, in Section 4, with some reflections on the nature of the evidence and the
limitations of the evidence base. We then summarise some key challenges for future research.
11Table 1.1
Search media Search fields No. of returns reviewed Notes
Academic Abstract, title, 1715 (Scopus) While Scopus and Web of Science
indices keywords 974 (Web of Science) are inherently academic indices,
99 (SocINDEX) ScoINDEX covers some grey literature
as well (e.g. the Economist).
Journals Full-text 3487 In total, there were 3487 returns
from all reviewed journals. Their
abstracts were reviewed and first-
phase exclusion criteria applied.
Newspapers Full-text 262 (reports) Newspapers reviewed using Nexis. The
leading UK newspapers - The Times,
39 (investigations) The Daily Telegraph, The Guardian, The
Independent, The Sunday Times, The
Sunday Telegraph and The Observer -
were selected for this investigation in
addition to review keywords. Results were
limited to ‘reports’ and ‘investigations’.
Core database Full-text 84 As a result of the review process, 84
publications were identified. This includes
reviewing indices, journals, grey literature
(including newspaper review), follow up
references, a very recent new publication
and an article which is outside the
timeframe but critical to the review.
Primary Full-text 50 After second phase exclusion, 50
Sources: Final articles were identified as relevant
Academic and above quality threshold, and
Database reviewed for evidence extraction.
Primary Full-text 12 After second phase exclusion, 12 grey literature
sources: Final publications were identified as relevant,
grey literature and reviewed for evidence extraction.
database
Secondary Full-text 8 After second phase exclusion, 8 secondary
sources sources were identified and reviewed. These
publications have not provided substantial
evidence, but are still relevant to the research.
12housingevidence.ac.uk
2. How has the industry been studied?
In this section, we include a brief summary of the theoretical and disciplinary perspectives and methods that
can be identified from the literature. We extracted this information from the literature following the same
process as the evidence review itself. We also provide a brief note on significant policy interventions. This
is followed, in Section 3, by a review of the evidence relating to each of the four key areas of enquiry.
2.1 Theoretical perspectives
Most of the literature on the housebuilding industry is remarkably atheoretical. As Figure 2.1 shows, we found that
over 70% of the papers we analysed did not seek to apply or test any particular theoretical perspective. These
papers were essentially practice or policy orientated in that they either explained what the authors had found out
about the industry or offered a review or critique of policy towards it, but without setting this within any theoretical
context, explicitly or even implicitly. Although these papers often provided helpful insight into the current operations
of the industry at the time of their publication, they were less useful in identifying how key drivers change over
time. This left less than 30% of papers where the authors had sought to apply or test a particular theoretical
perspective, either explicitly or implicitly. As Figure 2.1 shows, within these papers, the most popular approach
taken was that of grounding the paper within neoclassical economics, with institutional theories and environmental
or urban design theories achieving slightly less attention. These categories will now each be considered in turn.
Research in the neoclassical tradition has concentrated on exploring what Golland and Boelhouwer (2002:
231) define as “the relationships between new build output, housing markets and the wider economy”.
Here, there has been particular interest on how far new housing supply is responsive to demand, how this
varies both within the UK and internationally, how it is affected by the structure and organisation of the
housebuilding industry, and by the extent to which the industry can be considered competitive, locally,
regionally and nationally. Connections are often made in these studies to institutional analysis, especially in
evaluating how different forms of land use regulation impact on industry structure and company strategies
and on the speed at which supply responds to changing demand. Some of the work in this tradition, such
as that of Leishman (2001 and 2015) deploys econometric modelling to delve deeper into this issue.
4%
9%
No theoretical stance
15%
Neoclassical economic theories
Institutional theories
Environmental or urban
design theories
72%
Figure 2.1: Theoretical stance taken in papers reviewed by percentage.
13Those looking at the industry from an institutional perspective appear much more disparate in their conceptual frameworks. Among the papers reviewed here were those seeking to understand the industry from, for example, structure and agency approaches, different forms of network theory, and particular types of organisational or management theory. These papers often explored the social dynamics of housebuilding and provided social explanations of outcomes to reinforce or balance the economic explanations preferred in neoclassical analysis. But crucially, there seemed to be little connectivity between different institutional approaches. Certainly, no dominant institutional perspective emerged to challenge the more integrated nature of neoclassical analysis. Although there was much comment in the literature on the environmental and urban design outcomes of the housebuilding industry, very little of this was connected to theoretical debates in these areas. One exception was the attempt by Tiesdell and Adams (2004) and Adams, Croudace and Tiesdell (2011) to apply and develop the concept of ‘opportunity space theory’ in urban design to explain the circumstances in which design quality was or was not prioritised by different housebuilders. From this overview, a key research challenge emerges for future work on the housebuilding industry, which is that of developing a richer theoretical understanding of how the industry operates as a basis for stronger empirical investigation. 2.2 Disciplinary perspectives As research into housebuilding is multidisciplinary by its very nature, those with backgrounds in business management, construction, economics, geography, planning, policy analysis, real estate, sustainability and urban design were all represented in the range of papers analysed. Some outputs were very clearly grounded in the particular authors’ own discipline, as evident in the specialist work by economists on the market structure of the industry. Typically, however, papers on housebuilders and the housebuilding industry tended to draw on two or more disciplines. For example, we identified around 20 papers that explored how the planning system impacts on business organisation in housebuilding and another eight that looked at the relations between technical innovation in construction and business strategy. In some cases, work involved teams of researchers from different disciplinary backgrounds. For example, the investigation of Hertin et al. (2003) into how the housebuilders might adapt to climate change brought together academics with expertise in business management, economics, environmental science, geography, political science, public policy and technological innovation. In other cases, there was evidence of cross-disciplinary movement, especially of those with backgrounds in geography or planning moving in to investigate corporate strategy. Hooper and Nicol’s (1999 and 2000) work on standard house types provides an early instance of this, while Karadimitriou’s (2005 and 2013) later investigations into the business strategies of ‘brownfield builders’ offer a more recent example. Perhaps the most important lesson from all this is that housebuilding, as a research focus, demands inter-disciplinary flexibility as well as cross-disciplinary collaboration. Although single disciplinary approaches may well yield particularly-focused insights, a more rounded understanding of the operations of the industry and their broader consequences appears to require a range of different disciplinary perspectives. 2.3 Methods As well as a range of disciplinary perspectives, we found that studies used a number of different methods; but by far the most common were semi-structured interviews and survey questionnaires. Of the 62 primary sources we reviewed, more than one-third used some form of survey questionnaire. Postal surveys appear to be used more frequently in studies of this industry, followed by telephone and web-based surveys. Typically, housebuilders were 14
housingevidence.ac.uk
sampled on the basis of their size (usually measured by the number of units completed per year, according, for
example, to Wellings’ Private Housebuilding Annuals). Other sampling techniques include drawing samples from
membership lists. Gibb, McGregor and Munro (1997), for example, conducted a telephone survey targeting 150
members of the Scottish House Builders Association. In a study on the selection by housebuilders of low and zero-
carbon technologies, Lees and Sexton (2014) used National House Building Council mailing lists to invite members
who had expressed an interest in sustainability, to complete a web-based survey. Henderson, Ganah and John
(2016) started with a list of 143 housing developers from the Home Builders Federation database and surveyed every
second case. Respondents tended to be senior managers and response rates ranged from 36% to 65%, with most
tending to be about 40%. These are consistent with typical response rates for survey questionnaires in the social
sciences. Some studies, which focused on new-build housing preferences, quality and choice, surveyed new-build
consumers (Roy and Cochrane 1999; Barlow and Ozaki 2003; Leishman et al. 2004; Leishman and Warren 2006).
More than half of the 62 primary sources used semi-structured interviews with group directors and senior
managers of housebuilding companies, and other key stakeholders including landowners, planning authorities,
suppliers and/or industry representative bodies. Most of these studies deployed more than one method,
with interviews, for example, commonly used in conjunction with survey questionnaires. Interviewees were
often drawn from survey samples. Payne (2013), for example, first sought aggregate data at an industry level
through a postal questionnaire targeting the largest 104 housebuilders in the UK; and, secondly, captured
disaggregated data at the company level through detailed interviews with 11 companies operating in Greater
Manchester and Central Scotland. A number of other publications adopt a similar stepwise approach (e.g.
Gibb, McGregor and Munro, 1997; Gibb, 1999; Hooper and Nicol, 2000; Scottish Government, 2007; Osmani
and O’Reilly, 2009; Smith, Ferrari and Jenkins, 2011). Sampling techniques included purposive sampling (e.g.
Adams, Leishman and Watkins, 2012) and use of ‘snowballing’ (Lovell, 2005). Adams, Leishman and Watkins
(2012: 706) described their approach as an “internal referral process”, whereby interviewees were nominated
by colleagues on the basis of their intimate knowledge of the strategic priorities and practices of firms.
Other methods included direct observations, analysis of published information and company reports, as well as
focus groups and other methods of consultation (e.g. regional roundtables, seminars and meetings). As this shows,
the effective study of such a highly differentiated industry as UK housebuilding appears to require a combination of
methods and approaches, capable of generating quantitative and qualitative data at both industry and company level.
2.4 Significant policies
In the early 1980s, the state retreated from direct provision of new housing, when the then Conservative
government cut public expenditure on housing. This effectively outsourced housing provision to the market
and saw speculative housebuilders take on a primary delivery role. As a result, housing supply became more
susceptible to market cyclicality, leading to historic lows in starts and completions. Successive governments
have, with varying degrees of emphasis, sought to tackle this inherent cyclicality and volatility of provision.
Facilitative policies such as Help to Buy and the New Homes Bonus have encouraged new development
by stimulating demand and encouraging political buy-in, whilst regulatory policies like brownfield and
zero carbon targets have pushed housebuilders into new geographical and technological spheres. These
polices have been met with varying degrees of success and elucidate the challenges policy makers face in
their quest to deliver housing numbers, while also influencing the type and location of new homes.
The contradiction between policy reliance on the industry to deliver new homes and the frustration
that it does not necessarily result in the quantity or quality of new homes that policy makers want to
see is a reminder of the importance of regulation in housing markets. This is reflected in the series of
official reviews undertaken by Barker (2004), Callcutt (2007) and Letwin (2018), which have examined
the undersupply of new homes and recommended interventions to raise housing production.
153. The evidence In Section 2, we provided a brief account of how others have studied the UK housebuilding industry. This revealed key research challenges and important lessons for future research in this field. In this section, we turn our attention to the evidence that we have gathered from the literature, focusing specifically on the following four key areas of enquiry: land acquisition methods and processes; the composition of land portfolios and questions of land ‘banking’; product selection and the mode of delivery; and the speed of delivery of new housing supply, including build out rates. We take each of these areas of enquiry in turn and conclude each section with a short summary of the evidence 3.1 Land acquisition methods and processes Our research revealed relatively few publications that focus specifically on the land acquisition methods and processes of speculative housebuilders in the UK. Some contributions which purport to cover the full extent of the planning and delivery process are remarkably silent on land acquisition (for example, Nathaniel Lichfield and Partners, 2016). There are, however, three key contributions, each adopting a relatively similar theoretical stance and methodological approach, which shed light on the strategies, methods and processes of land acquisition prevalent in the UK speculative housebuilding industry. First, Adams, May and Pope (1992) specifically examined housebuilders’ strategies for the acquisition of residential development land and their involvement in the land use planning process. While this work is now quite dated, it remains relevant as subsequent work corroborates its findings. The second paper, by Adams, Leishman and Watkins (2012), for example, revealed the importance to housebuilders of networks with other important actors in securing future land supplies. Third, Payne (2013) examined how housebuilders respond to increasing state intervention in their business practices, specifically in relation to the policy switch favouring brownfield development in the early 2000s and its impact on housebuilders’ approaches to land acquisition and product design. These three papers are now considered in turn, while also supplemented by other studies and government reviews which reflect and comment on land acquisition without adding much in the way of additional empirical material. 3.1.1 Evidence on the use of options, conditional contracts and the land use planning process Of all the publications we reviewed for this report, the three papers mentioned above focus explicitly on land acquisition methods and processes. Adams, May and Pope (1992) explored both the acquisition of land for residential development and housebuilders’ increasingly sophisticated use of the planning process. The research was based on detailed case studies, drawing on local authority records and published information, along with interviews with landowners, developers and agents. The results showed that, from as early as the 1980s, opportunities to influence local planning were increasingly reflected in land acquisition strategies, which in turn were developed to allow for flexibility in negotiation with landowners and local planning authorities. Most housebuilders in the study acquired land without planning permission through either options or conditional contracts in order to spread risk and uncertainty, enable gradual purchase of land in multiple ownership, and reduce initial capital outlay (Adams, May and Pope, 1992: 211-2). These advantages to the developer of using options and conditional contracts over freehold purchase are echoed in other more recent reviews and studies (Barker, 2004: 129; Callcutt, 2007: 37; Payne, 2013: 41). Crucially, however, Adams, May and Pope (1992: 212) noted that developers did not seek to tie up land indiscriminately through options and conditional contracts. Instead, they participated in the process of planning policy formulation, utilising the land use planning process to their advantage and targeting their options and conditional contracts on land likely to be released. It is unclear, from the literature, how far this specific practice continues, but subsequent work, which we refer to below, suggests that housebuilders continue to rely on 16
housingevidence.ac.uk
external development networks and partnerships. Adams, May and Pope (1992: 214) found that local development
agents with considerable knowledge of local planning policy played a crucial role in land acquisition, acting on
behalf of housebuilders in their negotiations with local authorities, but also in identifying sites for development,
persuading landowners to release them and then finding appropriate developers and house purchasers.
It is worth noting that there is a cost to taking out an option. As the Callcutt Review (2007: 37) noted, “Landowners
observe the escalating prices of new homes, and can and do demand both a premium payment for the option
and a full share of development profits”. However, both Callcutt (2007) and Adams, May and Pope (1992: 224)
observed that, where payment is made to the landowner for the option, it is still less costly than purchasing
freehold (once planning consent is granted) and holding the site on the balance sheet at its full acquisition
value. Reducing the initial capital outlay in this way means that developers can “direct their resources, not
to expensive acquisition of freehold land, but rather to employing the best professional advice available to
secure the release of land under option, through both planning appeals and involvement in the local planning
process” (ibid). The results highlight the growth of planning consultancy, which the authors conclude “has
been engendered, in large measure, by the changing acquisition strategies of residential developers” (ibid).
3.1.2 Evidence on the use of networks and contacts
Building on this earlier work, Adams, Leishman and Watkins (2012: 706) aimed to “recast theoretical conceptions
of land markets away from the neo-classical model of competitive markets and towards a more institutionally
grounded notion of socially embedded networks of relations”. This research was based on in-depth semi-
structured interviews with senior representatives of 19 UK housebuilders (a stratified sample drawn from a
population of 87 listed by Wellings (2006) as completing 100 or more new units in 2005). The authors adopted
a purposive sampling approach to identify housebuilders broadly representative of the industry’s structure
resulting in the selection of four volume builders (annual output of over 2000 units), seven medium-sized
builders (501-2000 units), and eight smaller builders (101-500 units). This broad perspective was complemented
by an interview with a representative of the UK’s largest land agent who had interacted with many builders of
different types and sizes. The results showed that UK speculative housebuilders rely more on networks than
markets to source land and that they structure those networks to enhance their own competitive positions.
The authors highlighted three main reasons why housebuilders rely more on networks than markets. First, not all
residential development land is openly marketed. Land may be made available to closed tender (Adams, Leishman
and Watkins, 2012: 711) or may be exchanged or “swapped” between builders (see Callcutt, 2007: 141). Second,
“bullish bidding behaviour” by land buyers might not be authorised by senior management within the company;
instead, “the stronger the influence of the internal hierarchy, the more local managers must rely on external networks
for land acquisition, since to do otherwise might risk internal veto of the bullish land bids necessary to outbid all
competitors” (Adams, Leishman and Watkins, 2012: 712). And third, the best way to buy current (or short term) land
– that is land which has planning consent for residential development or has outline planning permission for that
purpose – is through contacts (ibid). The authors argued that “it has become common practice for housebuilders
to try to secure their land supplies at least two to three years in advance, often through options and contracts” and
to do this “housebuilders’ land buyers hunt out land and develop extensive contacts with potential vendors and
agents” (ibid: 706). Developers forge networks with other developers to share information, establish partnerships and
exchange land (ibid: 712-14); and they use options and conditional contracts to develop relationships with landowners
over a period of time (ibid: 714). This work resonated with that of Adams, May and Pope (1992), especially where
developers express a preference for dealing with experienced landowners who understand the planning process.
Similarly, the crucial intermediary role of development agents and the potential benefits of building closer
relationships with planners were again evident (Adams, Leishman and Watkins, 2012: 714-16). The authors
cited the “clash of cultures” between the private and public sectors as both a source of frustration and
an incentive to build closer relationships. Housebuilders have consistently complained about planning
constraints over the past two to three decades (Gibb, McGregor and Munro, 1997; Gibb, 1999; Barker, 2004;
17Ball, 2005; Callcutt, 2007; Goodier and Pan, 2010: 17; House of Lords, 2016). Adams, Leishman and Watkins (2012: 715-6) remarked that “We heard well-rehearsed complaints from housebuilders about the regulation of development through the planning system, emphasising planning delay, perceived inconsistent decision- making and political interference”; and they suggest that “the inability to articulate shared interests on both sides means that planners stand at the most distant point from housebuilder networks” (ibid: 716). Taken together, these two papers show that housebuilders’ land acquisition methods will usually involve the use of options and conditional contracts to reduce risk, uncertainty and initial capital outlay; that they utilise the land use planning process to target options and contracts on land likely to be released; and that housebuilders rely more on networks than markets to source land for residential development. We now turn to the third key contribution. 3.1.3 Evidence on the behavioural practices of housebuilders in relation to brownfield and greenfield development sites Payne (2013) specifically aimed to understand the behavioural practices of speculative housebuilders and to evaluate their response to state-led policy initiatives seeking to influence their business practices. More broadly, she sought to explain “why change may or may not occur” and “why some organisations respond to change through embedding new business practices, while others rely on only superficial modifications to their existing business practices” (ibid: 45). She focused on examining the policy switch favouring brownfield development, formally introduced in England in 2000 and adopted thereafter, albeit less formally, in Scotland and Wales, and on identifying its impact on housebuilders’ approaches to land acquisition and product design. The research was conducted in two stages. Stage one comprised quantitative methods in the form of aggregate data gathered via a postal questionnaire sent to 104 UK housebuilders (each with an annual output of over 100 units), which returned a 46% response rate. Responses were then categorised into typologies of brownfield development (see Payne, 2013: 47) from which a sample of 11 was drawn. In Stage two, in-depth semi- structured interviews were conducted with these 11 firms, based in Greater Manchester and Central Scotland. Payne (2013: 44) found that conventional land acquisition strategies and skills used for greenfield sites differed from those required for brownfield sites. She revealed a clear distinction in the response of speculative housebuilders to the brownfield policy agenda. In short, “a small cohort of housebuilders… sought to embed increasing rates of brownfield development within their existing business strategies”, while the majority “responded to the policy switch with notable caution, seeking to accommodate brownfield development within their conventional business model rather than making any fundamental changes to suit the demands of the policy switch” (ibid: 56). The former were labelled ‘pioneers’ (15% of the sample), while the latter were considered ‘pragmatists’ (56%) and ‘sceptics’ (29%). In terms of land acquisition, the pioneers, who tended to be regeneration specialists, “generally sought out large, stand-alone sites in need of significant regeneration, often with significant ground problems and in areas of low market demand, leaving smaller and ‘easier’ brownfield sites for the rest of the industry” (ibid: 49). This group rarely bought land outright, but relied instead on development agreements with landowners, agreeing a profit split in advance. Here Payne’s evidence reflects that of Dixon (2006), who also explored housebuilders’ willingness to take on and tackle difficult brownfield sites. Notably, Payne’s pragmatists and sceptics “were forced [as greenfield land opportunities decreased] to consider brownfield land for acquisition to maintain their flow of suitable development land in the short term and secure continued housing production” (Payne, 2013: 53). We return to the composition of land portfolios and questions of land ‘banking’ in the next Section 3.2. In constructing these typologies, Payne (2013) emphasised that housebuilders are not a homogenous group (see also Goodier and Pan, 2010: 11), although they are, by and large, risk averse. Their characteristic aversion to risk, while understandable, manifests in low levels of investment in brownfield development, which exacerbates market failures (i.e. externalities, co-ordination failures and information failures) typically associated with such developments (Barker, 2004: 56-7, 129). Payne (2013: 48-9) noted that the ‘pioneers’ tended to be small and to specialise in regeneration projects. The pragmatists tended to be volume and super builders, while the ‘sceptics’ were mostly small to 18
You can also read